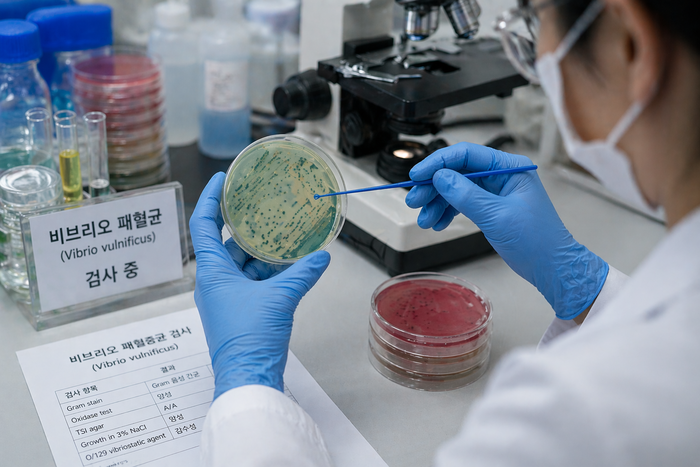
Photo Image

올해 첫 비브리오패혈증 환자가 발생해 방역당국이 주의를 당부했다.
질병관리청은 23일 “올해 첫 비브리오패혈증 환자가 확인됐다”고 밝혔다. 환자는 40대 남성으로, 간 질환 등 기저질환을 앓고 있었던 것으로 전해졌다.
이 남성은 지난 21일부터 다리 부위 부종과 통증 증상을 보여 경기도 한 병원에서 입원 치료를 받던 중, 23일 비브리오패혈증으로 확진됐다. 이후 증상이 급격히 악화되며 결국 사망했다.
비브리오패혈증은 비브리오 패혈균 감염으로 발생하는 질환으로, 해수와 갯벌, 어패류 등 연안 해양 환경에 널리 존재한다. 특히 해수 온도가 18도 이상으로 올라가는 4~6월 사이 첫 환자가 발생하고, 8~10월에 환자가 집중적으로 증가하는 경향을 보인다.
감염은 오염된 해산물을 날로 먹거나 충분히 익히지 않고 섭취할 때, 또는 상처가 있는 피부가 오염된 바닷물과 접촉할 때 발생한다. 주요 증상은 급성 발열과 오한, 혈압 저하, 복통, 구토, 설사 등이며, 발병 후 24시간 이내 다리 부위에 발진과 부종, 출혈성 수포 등 피부 병변이 나타나는 것이 특징이다.
특히 만성 간 질환자나 당뇨병 환자, 알코올 의존자 등 기저질환을 가진 고위험군은 감염 시 치사율이 50% 안팎에 달해 각별한 주의가 요구된다. 항암 치료 중이거나 면역 기능이 저하된 환자, 장기이식 환자 등도 고위험군에 포함된다.
질병관리청은 예방을 위해 어패류를 충분히 익혀 섭취하고, 피부에 상처가 있을 경우 바닷물 접촉을 피할 것을 권고했다.
임승관 질병관리청장은 “비브리오패혈증은 예방수칙 준수와 함께 증상 발생 시 신속한 치료가 무엇보다 중요하다”며 “특히 고위험군은 각별한 주의가 필요하다”고 강조했다.
이상목 기자 mrlsm@etnews.com



















